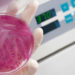

Le pathogène
L’agent principal est Mycoplasma agalactiae, bien que chez les chèvres, on puisse également trouver Mycoplasma mycoides subsp. capri, Mycoplasma capricolum subsp. capricolum et Mycoplasma putrefaciens.
Comment survient la maladie ?
La transmission peut être oro-nasale, par écoulement nasal ou oculaire, ou par excrétion de lésions articulaires d’animaux infectés. Les surfaces contaminées sont la source d’infection, comme les mangeoires, les abreuvoirs ou la litière. Les chevreaux ou les agneaux peuvent être infectés par le colostrum ou le lait.

Les femelles sont également infectées par voie mammaire, via les manchons ou la main des trayeurs, qui peuvent être contaminés.
Les femelles sont principalement infectées par voie mammaire, via des manchons contaminés
Lorsque l’animal s’infecte, le pathogène se multiplie puis se propage dans les organes cibles : glande mammaire, poumon, yeux, articulations… Les symptômes comprennent la mammite, la pneumonie, la kératoconjonctivite, l’arthrite, la septicémie, les fausses couches occasionnelles et l’orchite chez les mâles.
Les troupeaux peuvent souffrir d’épidémies ou d’infections chroniques, avec une incidence élevée de mammite subclinique. Les infections chroniques sont fréquentes dans les troupeaux de chèvres, où il existe des porteurs asymptomatiques.
Les porteurs asymptomatiques maintiennent la maladie dans le troupeau
Que se passe-t-il au niveau du pis ?
Au début, le pis semble gonflé et chaud, puis il devient flasque et plein de tissu conjonctif. Dans cette phase, le lait devient plus liquide, jaunâtre ou verdâtre (et peut devenir purulent) et sa production est réduite.
Enfin, le pis s’atrophie et l’agalaxie survient en raison de la nécrose de l’épithélium glandulaire et de la compression exercée par la fibrose du tissu.
L’infection provoque une atrophie du pis et, par conséquent, la production de lait cesse
Conclusions
● Étiologie diverse.
● Grande variabilité des symptômes.
● Présence de porteurs asymptomatiques.
● Fort impact économique dû à la perte de production laitière.
Article rédigé par:
Tania Perálvarez Puerta. Product Manager Small Ruminants Unit – HIPRA